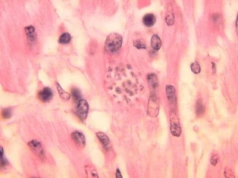
„Choroba całujących pluskiew” rozprzestrzenia się. Zarażonych 280 tys. osób?

Andrew Tate stracił 280 tys. zł na tokenie Trumpa, ale zaraz otworzył nową pozycję
źródło: https://otokrypto.pl/tate-stracil-280-tys-zl-na-wlfi
dodano: 02-09-2025 13:51:07
Inne znaleziska:
Gigant stracił 280 miliardów dolarów w jeden dzień. AI mania dostała zimny prysznic
Gigant stracił 280 miliardów dolarów w jeden dzień. AI mania dostała zimny prysznic
Broadcom zaliczył zderzenie z oczekiwaniami Wall Street. Spółka pokazała dobre wyniki, ale jedna słabsza prognoza dla chipów AI wystarczyła. Artykuł Gigant stracił 280 miliardów dolarów w jeden dzień. AI mania dostała zimny prysznic pochodzi z serwis...
bithub.pl
05-06-2026 07:14:14
05-06-2026 07:14:14
Andrew Tate: „Bitcoin spadnie do 26 tys. dol.” Czy rynek faktycznie zmierza na dno?
Andrew Tate: „Bitcoin spadnie do 26 tys. dol.” Czy rynek faktycznie zmierza na dno?
Popularny, kontrowersyjny influencer z manosfery, Andrew Tate, uważa że BTC może spaść do 26 tys. dolarów za sztukę. Dlaczego? Artykuł Andrew Tate: „Bitcoin spadnie do 26 tys. dol.” Czy rynek faktycznie zmierza na dno? pochodzi z serwisu BitHub.pl.
bithub.pl
19-10-2025 17:20:07
19-10-2025 17:20:07
„Choroba całujących pluskiew” rozprzestrzenia się. Zarażonych 280 tys. osób?
„Choroba całujących pluskiew” rozprzestrzenia się. Zarażonych 280 tys. osób?
Wywoływana przez tzw. całujące się pluskwy choroba Chagasa pojawia się w kolejnych regionach USA. Centrum Kontroli i Zapobiegania Chorobom (CDC) donosi o potwierdzonych przypadkach już w 8 stanach.
wprost.pl
09-09-2025 10:17:08
09-09-2025 10:17:08
Za plan ogólny gminy płacą nawet 280 tys. zł. Jedna skarga może to zmarnować
Za plan ogólny gminy płacą nawet 280 tys. zł. Jedna skarga może to zmarnować
Za plan ogólny gminy płacą nawet 280 tys. zł. Jedna skarga może to zmarnować
bezprawnik.pl
19-04-2026 18:39:14
19-04-2026 18:39:14
Ewa Minge zabrała tatę do "halo tu polsat". Gorzko wypowiedziała się o jury "Tańca z gwiazdami"
Ewa Minge zabrała tatę do "halo tu polsat". Gorzko wypowiedziała się o jury "Tańca z gwiazdami"
Ewa Minge pojawiła się w śniadaniówce Polsatu wraz z tatą. W pewnym momencie poruszono temat "Tańca z gwiazdami". Projektantka wspomniała o ocenach jury.
plotek.pl
21-09-2025 17:28:18
21-09-2025 17:28:18
Mało kto wie, że Baron ma ZNANEGO tatę. Też robi KARIERĘ w branży muzycznej
Mało kto wie, że Baron ma ZNANEGO tatę. Też robi KARIERĘ w branży muzycznej
Baron z zespołu Afromental pochwalił się na Instagramie filmikiem, na którym muzykuje w towarzystwie swojego taty. Jego ojciec jest wybitnym saksofonistą, o czym mogło nie wiedzieć wielu fanów "The Voice of Poland".
jastrzabpost.pl
18-10-2025 18:02:08
18-10-2025 18:02:08
Elżbieta Romanowska prosi o wsparcie. Opublikowała przejmujący apel, chodzi o jej tatę
Elżbieta Romanowska prosi o wsparcie. Opublikowała przejmujący apel, chodzi o jej tatę
Elżbieta Romanowska podzieliła się z fanami poruszającą wiadomością za pośrednictwem Instagrama. Gwiazda programu "Nasz nowy dom" przekazała, że jej tata walczy o życie w szpitalu. Poprosiła swoich obserwatorów o wsparcie.
party.pl
21-10-2025 23:31:06
21-10-2025 23:31:06
Isabelle Tate nie żyje. Aktorka miała zaledwie 23 lata
Isabelle Tate nie żyje. Aktorka miała zaledwie 23 lata
Nie żyje Isabelle Tate, młoda aktorka znana z roli w serialu ABC "9-1-1: Nashville". Informację o jej śmierci przekazała agencja McCray z Nashville, która reprezentowała artystkę. Tate miała 23 lata. Przyczyna jej odejścia nie została ujawniona.
kultura.onet.pl
23-10-2025 22:41:32
23-10-2025 22:41:32
Dramat w galerii Tate Modern. Zrzucił 6-latka z 10. piętra. Rodzina przekazała nowe wieści
Dramat w galerii Tate Modern. Zrzucił 6-latka z 10. piętra. Rodzina przekazała nowe wieści
To historia, która poruszyła cały świat. W sierpniu 2019 r. mający zaledwie sześć lat chłopiec z Francji został brutalnie wyrzucony z 10. piętra londyńskiej galerii sztuki Tate Modern. Sprawcą tego szokującego czynu był 17-letni Jonty Bravery, który...
fakt.pl
26-10-2025 23:17:16
26-10-2025 23:17:16
"Dziękuję ci za to, kim jestem". Martyna Wojciechowska wspomina tatę niecały rok po jego śmierci
"Dziękuję ci za to, kim jestem". Martyna Wojciechowska wspomina tatę niecały rok po jego śmierci
Ten dzień jest wyjątkowo trudny dla Martyny Wojciechowskiej — to pierwsze Wszystkich Świętych bez jej taty. Dziennikarka uczciła pamięć zmarłego ojca w poruszającym wpisie. "Śmierć nie kończy miłości" — napisała.
plejada.pl
01-11-2025 21:52:15
01-11-2025 21:52:15